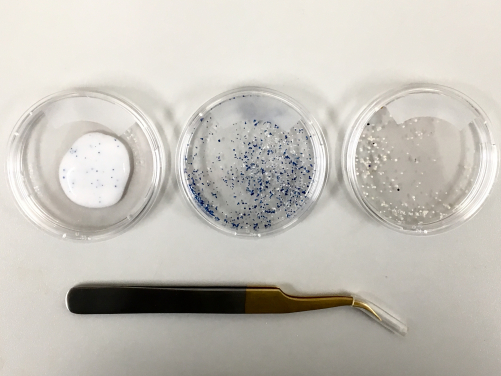
Microbeads in products (left), microbeads sieved from products (middle), microbeads recovered from water samples (right).

Media
HKU Earth Science study finds that most of the coastal waters of Hong Kong are polluted by plastic microbeads
03 Jul 2018
A research team from the University of Hong Kong has found that more than 60% of water samples from Hong Kong contain plastic microbeads. These microbeads originate from the usage of personal care or cosmetic products such as facial scrubs and toothpaste. While most are retained by the water treatment systems, there is still a huge number of microbeads that finds its way into our oceans. This study reveals that concentrations of up to 380,000 microbeads per square kilometer of ocean can be found around Hong Kong. While pollution of plastic bags and straws poses a threat to the oceans, contamination by plastic microbeads should not be overlooked.
This research was led by research assistants Mandy So, Kayi Chan and their supervisor Dr. Christelle Not, Assistant Professor from the Department of Earth Sciences and the Swire Institute of Marine Science. It was recently published in Marine Pollution Bulletin, a leading international journal on the issue of plastic pollution.
Plastic pollution of the oceans is a pervasive problem. Of special concern are “microplastics”, which are plastic pieces that are less than 5 mm in size. Microplastics are now ubiquitous in the world’s oceans as it is not possible to remove these particles once they have been introduced. Various studies have shown that numerous marine animals are consuming microplastics. Many of these animals then end up on our dinner plates. The consequences to the environment, marine organisms, and human health are as yet unknown.
Microbeads are a particular type of microplastic. They are microplastic particles specially designed to be smaller than 1 mm in size. They can be different colours (transparent, white, blue, black, etc.) and shapes (spherical, grape-like or irregular). Microbeads are most commonly used in personal care and cosmetic products. Consequently, they are intended to be ditched down the drain during their usage. Difficulties in their identification and collection means that very little research has been conducted to quantify the quantity of microbeads present in coastal waters.
Over 100 water samples from seven sites around Hong Kong were collected by the local NGO, Plastic Free Seas, during their outreach program. More than 60% of the water samples contained microbeads; therefore, microbeads represent a non-negligible quantity (approximately 5%) of the total amount of microplastic pollution found in Hong Kong waters. This study only examined microbeads that were 0.3 mm to 1 mm in size. However, microbeads smaller than 0.3 mm are utilized in products. “Consequently these results are an underestimation and the real quantity of microbeads is obviously higher” said Dr. Not.
The majority of microbeads collected in this study were transparent and composed of polyethylene. A previous study found that the majority of microbeads in locally sold personal care and cosmetic products were transparent and composed of polyethylene1. Thus, the microbeads recovered in this study were most likely from products sold in Hong Kong used by local citizens.
Microbeads in personal care and cosmetic products represent an unnecessary form of plastic pollution as they can easily be substituted by all-natural exfoliants such as sugar, salt, oatmeal, etc. As a result, many countries such as the United Kingdom, Canada, and New Zealand as well as several states in the United States of America have banned the usage of microbeads. Several private sector companies have also pledged to phase out the use of microbeads from their products. Despite these bans, the presence of microbeads in Hong Kong waters suggests that these products are still in use locally and still making their way into the ocean. “Microbeads are generally listed as polyethylene (PE) on the ingredient list of personal care and cosmetic products. To use or not to use is always the choice of the consumers. However, by choosing to not use products with microbeads, you can contribute to reducing plastic pollution with just a small change in habit,” said Miss So.
1Cheung, P.K., Fok, L., 2017. Characterisation of plastic microbeads in facial scrubs and their estimated emissions in Mainland China. Water Res. 122, 53–61.
Link of the article:
https://www.sciencedirect.com/science/article/pii/S0025326X18303953
More on the Environmental Geochemistry and Oceanography research group led by Dr Christelle Not: http://web.hku.hk/~bthib/
For media enquiries, please contact Ms Cindy Chan, Senior Communication Manager of HKU Faculty of Science (tel: 3917 5286/ 6703 0212; email: cindycst@hku.hk ) or Dr Christelle Not (email: cnot@hku.hk)
Image download: http://www.scifac.hku.hk/news/media?page=1